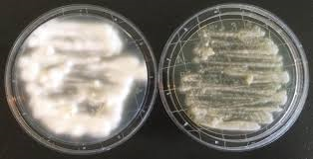

1
Q

A
1- Paracoccidioides brasiliensis
Leme de Navio / Mickey
2
Q

A
2- Paracoccidioides brasiliensis
SNC
3
Q

A
3- Paracoccidioides brasiliensis
Granuloma SNC
4
Q

A
4- Paracoccidioides brasiliensis
Histopatológico (Gomori-Grocott)
Leme de Navio / Mickey
5
Q

A
5- Paracoccidioides brasiliensis
Dimorfismo (25-37)
6
Q
A
6- Paracoccidioides brasiliensis
Dimorfismo (25-37)
7
Q

A
7- Paracoccidioides brasiliensis
Dimorfismo (25-37)
8
Q

A
8- Paracoccidioides brasiliensis
Evolução
9
Q

A
9- Paracoccidioides brasiliensis
Histopatológico
10
Q

A
10- Paracoccidioides brasiliensis
Histopatológico
11
Q

A
11- Paracoccidioides brasiliensis
Radiologia


